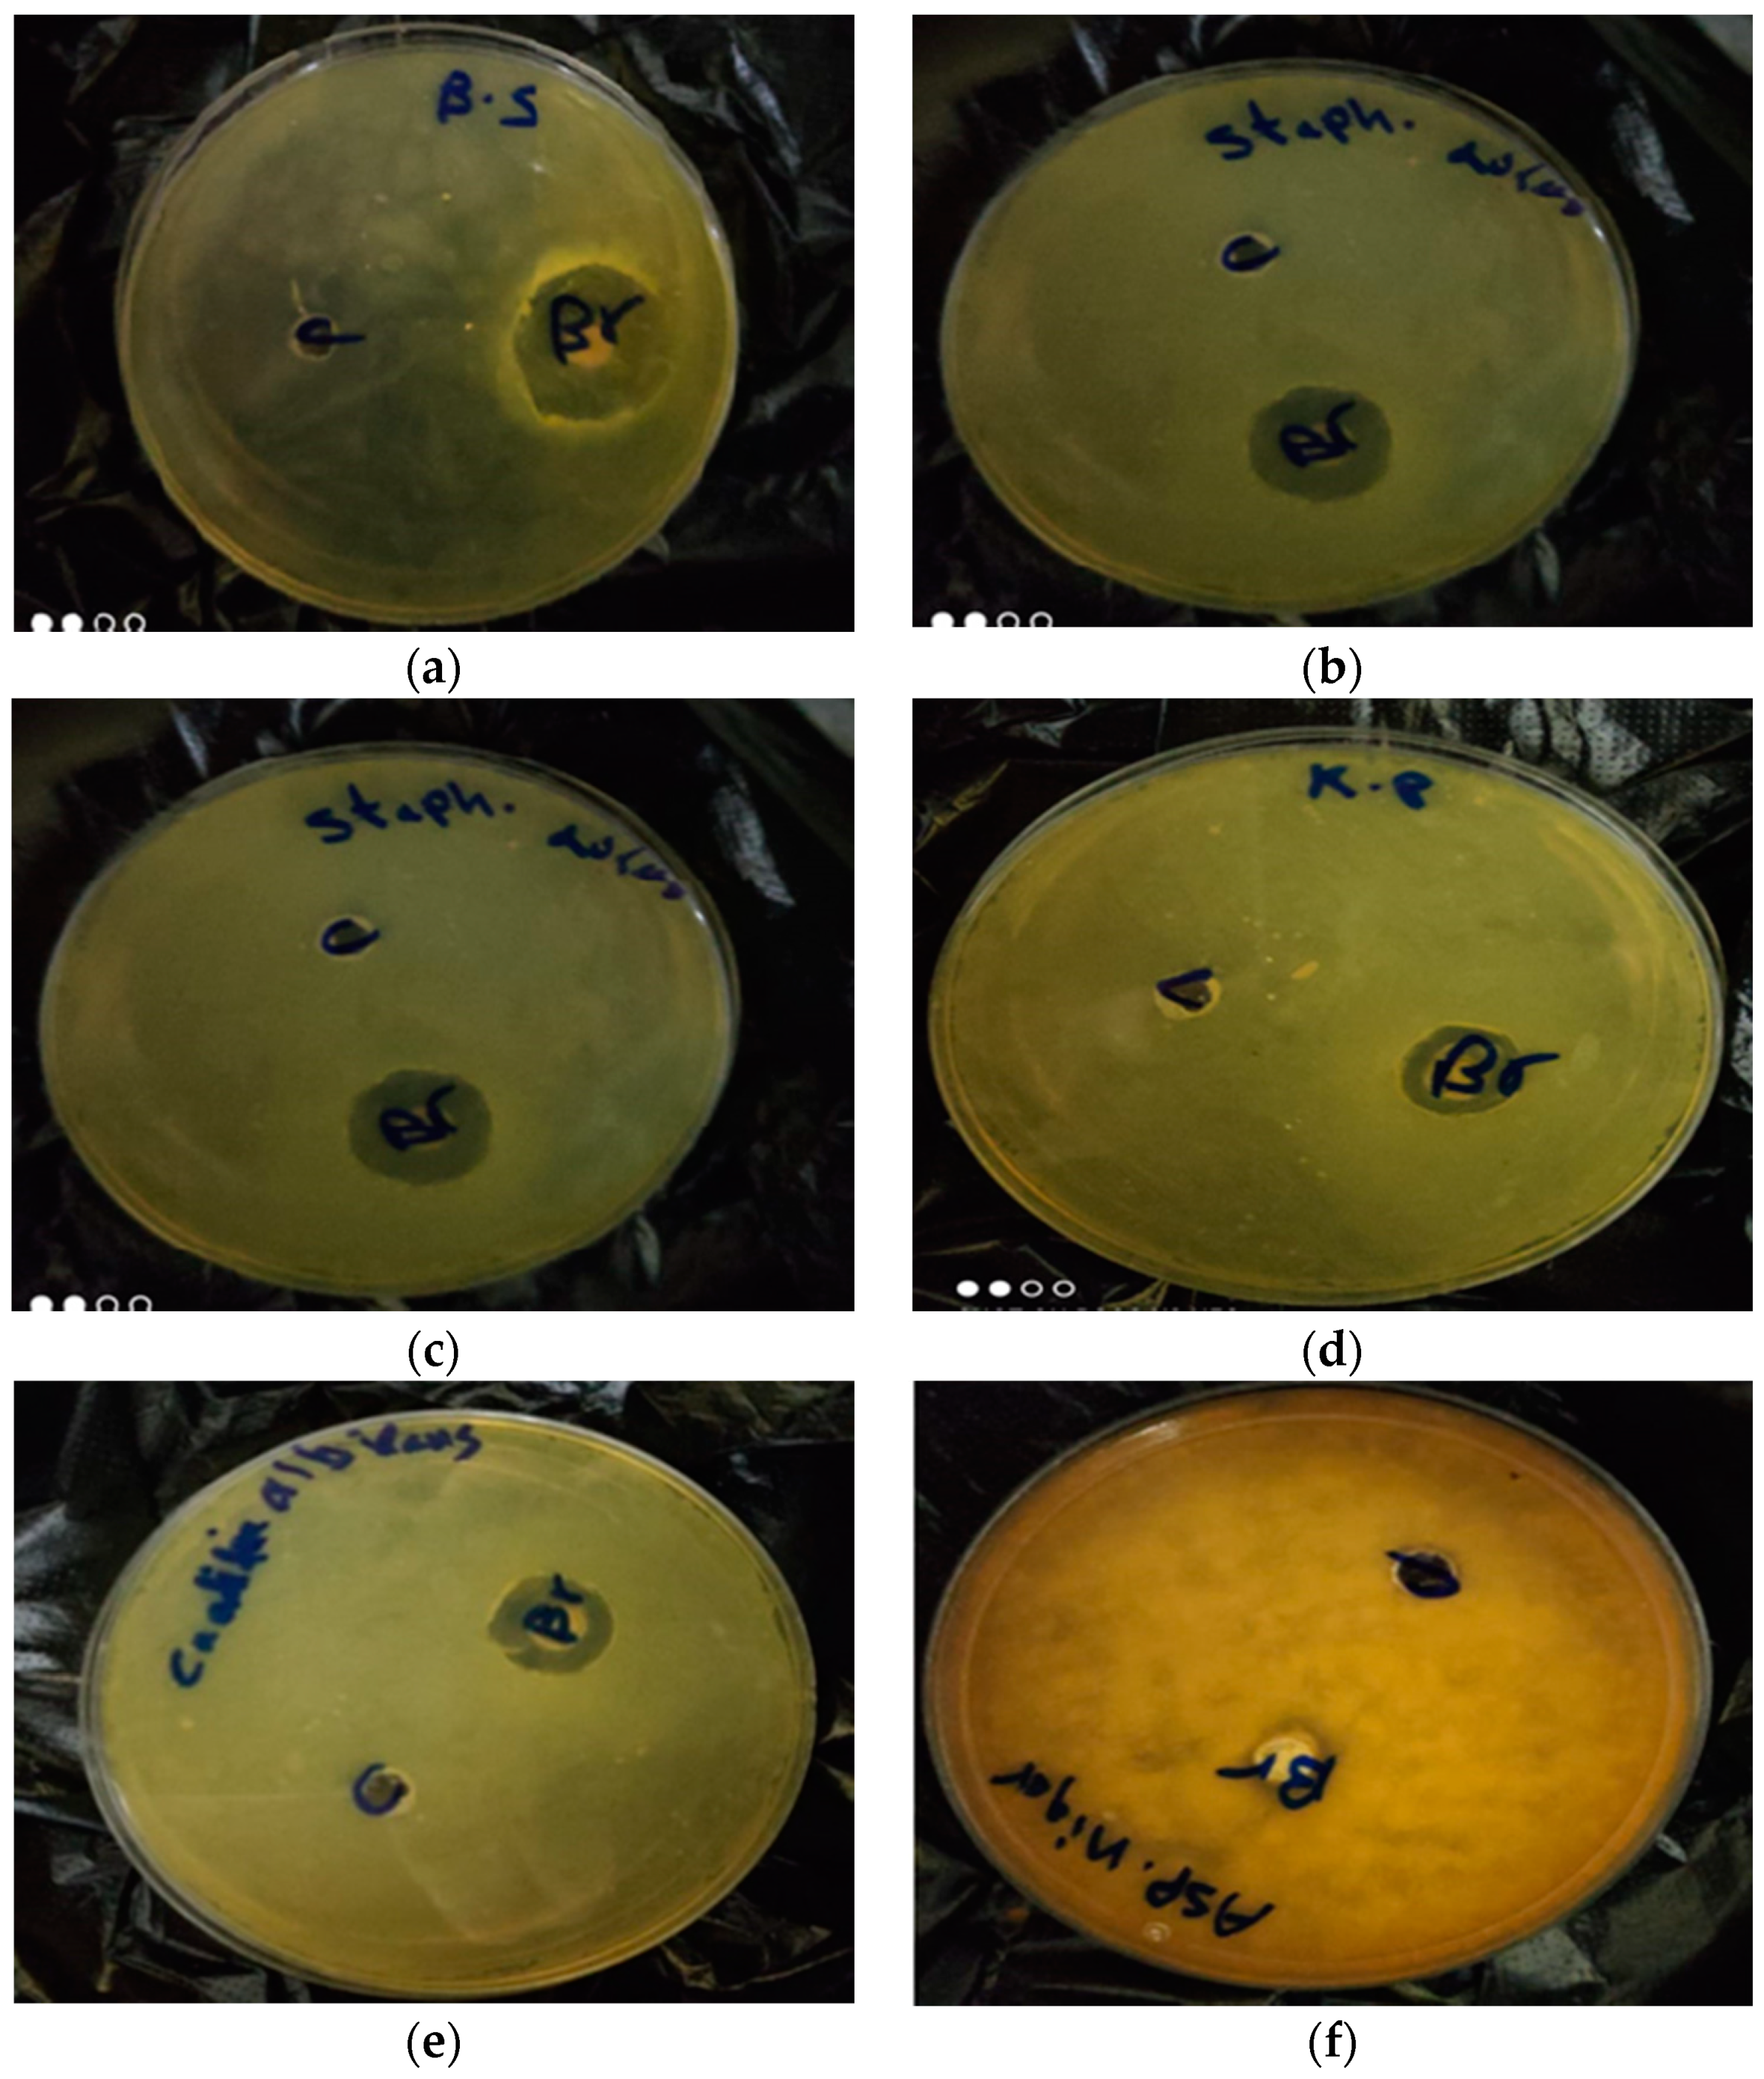
Molecules 26 02433 g002

In Vitro Antimicrobial, Antioxidant and Anticancer Activities of Egyptian Citrus Beebread
Abstract
1. Introduction
2. Results and Discussion
2.1. Palynological Examination of the Beebread
2.2. Nutritional Value of Beebread
2.2.1. Mineral Determination
2.2.2. Fatty Acids Determination
2.3. Bioactive Properties of Beebread
2.3.1. Total Phenolic and Flavonoid Contents
2.3.2. HPLC Analysis of Phenolic Compounds
2.4. Antioxidant Activity
2.5. Antimicrobial Activity of Beebread
2.6. Cell Viability Assay
3. Materials and Methods
3.1. Collection of Beebread Sample
3.2. Palynological Examination of the Beebread
3.3. Chemicals
3.4. Preparation of Beebread Extract
3.5. Analysis of Nutritional Value of Beebread
3.6. Mineral Composition
3.7. Free Sugars
3.8. Identified Fatty Acids Using Gas Chromatography–Mass Spectrometry Analysis (GC–MS)
3.9. Bioactive Properties of Beebread
3.10. Antimicrobial Activities
3.11. The Viability of Control and Treated Cells Were Evaluated Using the MTT Assay
3.12. Statistical Analysis
4. Conclusions
Author Contributions
Funding
Institutional Review Board Statement
Informed Consent Statement
Data Availability Statement
Acknowledgments
Conflicts of Interest
Sample Availability
References
- Yen, P.P.L.; Kitts, D.D.; Pratap-Singh, A. Natural Acidification with Low-pH Fruits and Incorporation of Essential Oil Con-stituents for Organic Preservation of Unpasteurized Juices. J. Food Sci. 2018, 83, 2039–2046. [Google Scholar] [CrossRef] [PubMed]
- Urcan, A.; Mărghitaș, L.A.; Dezmirean, D.S.; Bobiș, O.; Bonta, V.; Mureșan, C.I. Chemical composition and biological activities of beebread-review Bulletin UASVM. Anim. Sci. Biotechnol. 2017, 74, 6–14. [Google Scholar] [CrossRef]
- Zuluaga, C.M.; Serrato, J.; Quicazán, M. Chemical, nutritional and bioactive characterization of Colombian bee-bread. Chem. Eng. 2015, 43, 175–180. [Google Scholar] [CrossRef]
- Baltrušaitytė, V.; Venskutonis, P.R.; Čeksterytė, V. Radical scavenging activity of different floral origin honey and beebread phenolic extracts. Food Chem. 2007, 101, 502–514. [Google Scholar] [CrossRef]
- Bakour, M.; Al-Waili, N.S.; El Menyiy, N.; Imtara, H.; Figuira, A.C.; Al-Waili, T.; Lyoussi, B. Antioxidant activity and protective effect of bee bread (honey and pollen) in aluminum-induced anemia, elevation of inflammatory makers and hepatorenal toxicity. J. Food Sci. Technol. 2017, 54, 4205–4212. [Google Scholar] [CrossRef] [PubMed]
- Donadio, S.; Carrano, L.; Brandi, L.; Serina, S.; Soffientini, A.; Raimondi, E.; Montanini, N.; Sosio, M.; Gualerzi, C.O. Targets and assays for discovering novel antibacterial agents. J. Biotechnol. 2002, 99, 175–185. [Google Scholar] [CrossRef]
- Hearst, R.; Nelson, D.; McCollum, G.; Millar, B.C.; Maeda, Y.; Goldsmith, C.E.; Rooney, P.J.; Loughrey, A.; Rao, J.; Moore, J.E. An examination of antibacterial and antifungal properties of constituents of Shiitake (Lentinula edodes) and Oyster (Pleurotus ostreatus) mushrooms. Complement. Ther. Clin. Pr. 2009, 15, 5–7. [Google Scholar] [CrossRef] [PubMed]
- Marks, L.R.; Clementi, E.A.; Hakansson, A.P. The Human Milk Protein-Lipid Complex HAMLET Sensitizes Bacterial Pathogens to Traditional Antimicrobial Agents. PLoS ONE 2012, 7, e43514. [Google Scholar] [CrossRef] [PubMed]
- Sobral, F.; Sampaio, A.; Falcão, S.; Queiroz, M.J.R.; Calhelha, R.C.; Vilas-Boas, M.; Ferreira, I.C. Chemical characterization, antioxidant, anti-inflammatory and cytotoxic properties of bee venom collected in Northeast Portugal. Food Chem. Toxicol. 2016, 94, 172–177. [Google Scholar] [CrossRef]
- Morais, M.; Moreira, L.; Feás, X.; Estevinho, L.M. Honeybee-collected pollen from five Portuguese Natural Parks: Palynological origin, phenolic content, antioxidant properties and antimicrobial activity. Food Chem. Toxicol. 2011, 49, 1096–1101. [Google Scholar] [CrossRef]
- Kaplan, M.; Karaoglu, Ö.; Eroglu, N.; Silici, S. Fatty Acids and Proximate Composition of Beebread. Food Technol. Biotechnol. 2016, 54, 497–504. [Google Scholar] [CrossRef]
- Bakour, M.; Fernandes, Â.; Barros, L.; Sokovic, M.; Ferreira, I.C.; Lyoussi, B. Bee bread as a functional product: Chemical composition and bioactive properties. LWT 2019, 109, 276–282. [Google Scholar] [CrossRef]
- Campos, M.G.R.; Bogdanov, S.; De Almeida-Muradian, L.B.; Szczesna, T.; Mancebo, Y.; Frigerio, C.; Ferreira, F. Pollen composition and standardisation of analytical methods. J. Apic. Res. 2008, 47, 154–161. [Google Scholar] [CrossRef]
- Bonvehí, J.S.; Jordà, R.E. Nutrient Composition and Microbiological Quality of Honeybee-Collected Pollen in Spain. J. Agric. Food Chem. 1997, 45, 725–732. [Google Scholar] [CrossRef]
- Andjelkovic, B.; Jevtic, G.; Markovic, J.; Mladenovic, M.; Pseva, V. Quality of honey beebread collected in spring. J. Hyg. Eng. Des. 2012, 1, 275–277. [Google Scholar]
- Stanciu, O.G.; Marghitas, L.A.; Dezmirean, D. Macro-and oligo-mineral elements from honeybee-collected pollen and beebread harvested from Transylvania (Romania). Bull. UASVM Anim. Sci. Biotechnol. 2009, 66, 1–2. [Google Scholar] [CrossRef]
- Loper, G.M.; Standifer, L.N.; Thompson, M.; Gilliam, M. Biochemistry and microbiology of bee-collected almond (prunus dulcis) pollen and bee bread. I—Fatty Acids, Sterols, Vitamins and Minerals. Apidologie 1980, 11, 63–73. [Google Scholar] [CrossRef]
- Isidorov, V.A.; Isidorova, A.G.; Sczczepaniak, L.; Czyzewska, U. Gas chromatographic-mass spectrometric investigation of volatile and extractable compounds of crude royal jelly. J. Chromatogr. B 2012, 885, 109–116. [Google Scholar] [CrossRef] [PubMed]
- Čeksteryte, V.; Navakauskiene, R.; Treigyte, G.; Jansen, E.; Kurtinaitiene, B.; Dabkevičiene, G. Fatty acid profiles of monofloral clover beebread and pollen and proteomics of red clover (Trifolium pratense) pollen. Biosci. Biotechnol. Biochem. 2016, 80, 2100–2108. [Google Scholar] [CrossRef][Green Version]
- Čeksterytė, V.; Račys, J.; Kaškonienė, V.; Venskutonis, P.R. Fatty acid composition in beebread. Biologija 2008, 54, 253–257. [Google Scholar] [CrossRef]
- Codex Alimentarius Commission. Joint FAO/WHO Food Standards Programme. Codex Committee on Nutrition and Foods for Special Dietary Uses. In Proceedings of the Proposed Drsft Guidelines for Ready-to-Use Therapeutic Foods, Thirty-Ninth Session, Berlin, Germany, 3–7 November 2003. [Google Scholar]
- Simopoulos, A.P. Omega-3 fatty acids in health and disease and in growth and development. Am. J. Clin. Nutr. 1991, 54, 438–463. [Google Scholar] [CrossRef]
- Kitts, D.D.; Singh, A.; Fathordoobady, F.; Doi, B.; Pratap-Singh, A. Plant Extracts Inhibit the Formation of Hydroperoxides and Help Maintain Vitamin E Levels and Omega-3 Fatty Acids During High Temperature Processing and Storage of Hempseed and Soybean Oils. J. Food Sci. 2019, 84, 674–688. [Google Scholar] [CrossRef] [PubMed]
- Nation, J.L. Insect Physiology and Biochemistry; CRC Press: Boca Raton, FL, USA, 2002; 485p, ISBN 0-8493-1181-0. [Google Scholar]
- Simopoulos, A.P. Omega-3 Fatty Acids and Antioxidants in Edible Wild Plants. Biol. Res. 2004, 37, 263–277. [Google Scholar] [CrossRef] [PubMed]
- Erasmus, U. Lipids that Heal, Lipids that Kill the Complete Guide to Lipids, Oils, Cholesterol and Human Health; Alive Books: Burnaby, BC, Canada, 1996. [Google Scholar]
- Willett, W.C. The role of dietary n-6 fatty acids in the prevention of cardiovascular disease. J. Cardiovasc. Med. 2007, 8, S42–S45. [Google Scholar] [CrossRef] [PubMed]
- Urcan, A.C.; Criste, A.D.; Dezmirean, D.S.; Mărgăoan, R.; Caeiro, A.; Campos, M.G. Similarity of Data from Bee Bread with the Same Taxa Collected in India and Romania. Molecules 2018, 23, 2491. [Google Scholar] [CrossRef]
- Markiewicz-Żukowska, R.; Naliwajko, S.K.; Bartosiuk, E.; Moskwa, J.; Isidorov, V.; Soroczyńska, J.; Borawska, M.H. Chemical composition and antioxidant activity of beebread, and its influence on the glioblastoma cell line (U87MG). J. Apic. Sci. 2013, 57, 147–157. [Google Scholar] [CrossRef]
- Ivanišová, E.; Kačániová, M.; Frančáková, H.; Petrová, J.; Hutková, J.; Brovarskyi, V.; Velychko, S.; Adamchuk, L.; Schubertová, Z.; Musilová, J. Bee bread—Perspective source of bioactive compounds for future. Potravin. Slovak J. Food Sci. 2015, 9, 592–598. [Google Scholar] [CrossRef]
- Sobral, F.; Calhelha, R.C.; Barros, L.; Dueñas, M.; Tomás, A.; Santos-Buelga, C.; Vilas-Boas, M.; Ferreira, I.C.F.R. Flavonoid Composition and Antitumor Activity of Bee Bread Collected in Northeast Portugal. Molecules 2017, 22, 248. [Google Scholar] [CrossRef]
- Lamson, D.W.; Brignall, M.S. Antioxidants and cancer, part 3: Quercetin. Altern. Med. Rev. A J. Clin. Ther. 2000, 5, 196–208. [Google Scholar]
- Akhir, R.A.M.; Abu Bakar, M.F.; Sanusi, S.B. Antioxidant and antimicrobial activity of stingless bee bread and propolis extracts. In AIP Conference Proceedings; AIP Publishing LLC: Melville, NY, USA, 2017; Volume 1891. [Google Scholar] [CrossRef]
- Pratap-Singh, A.; Fathordoobady, F.; Guo, Y.; Singh, A.; Pratap-Singh, A. Antioxidants help favorably regulate the kinetics of lipid peroxidation, polyunsaturated fatty acids degradation and acidic cannabinoids decarboxylation in hempseed oil. Sci. Rep. 2020, 10, 10567. [Google Scholar] [CrossRef]
- Zerdani, I.; Abouda, Z.; Kalalou, I.; Faid, M.; Ahami, M. The Antibacterial Activity of Moroccan Bee Bread and Bee-Pollen (Fresh and Dried) against Pathogenic Bacteria. Res. J. Microbiol. 2011, 6, 376–384. [Google Scholar] [CrossRef]
- AbdElsalam, E.; Foda, H.S.; Abdel-Aziz, M.S.; Abd El-Hady, F.K. Antioxidant and Antimicrobial activities of Egyptian Bee Pollen. Middle East J. Appl. 2018, 8, 1248–1255. [Google Scholar]
- Yao, L.; Jiang, Y.; D’Arcy, B.; Singanusong, R.; Datta, N.; Caffin, N.; Raymont, K. Quantitative High-Performance Liquid Chromatography Analyses of Flavonoids in AustralianEucalyptusHoneys. J. Agric. Food Chem. 2004, 52, 210–214. [Google Scholar] [CrossRef]
- Bakchiche, B.; Temizer, İ.K.; Güder, A.; Çelemli, Ö.G.; Yegin, S.Ç.; Bardaweel, S.K.; Ghareeb, M.A. Chemical Composition and Biological Activities of Honeybee Products from Algeria. Appl. Biotechnol. Rep. 2020, 7, 93–103. [Google Scholar] [CrossRef]
- Kamonwannasit, S.; Nantapong, N.; Kumkrai, P.; Luecha, P.; Kupittayanant, S.; Chudapongse, N. Antibacterial activity of Aquilaria crassna leaf extract against Staphylococcus epidermidis by disruption of cell wall. Ann. Clin. Microbiol. Antimicrob. 2013, 12, 20. [Google Scholar] [CrossRef]
- Manning, R. Fatty acids in pollen: A review of their importance for honey bees. Bee World 2001, 82, 60–75. [Google Scholar] [CrossRef]
- Desbois, A.P.; Smith, V.J. Antibacterial free fatty acids: Activities, mechanisms of action and biotechnological potential. Appl. Microbiol. Biotechnol. 2010, 85, 1629–1642. [Google Scholar] [CrossRef] [PubMed]
- Louzada, S.; Adega, F.; Chaves, R. Defining the Sister Rat Mammary Tumor Cell Lines HH-16 cl.2/1 and HH-16.cl.4 as an In Vitro Cell Model for Erbb2. PLoS ONE 2012, 7, e29923. [Google Scholar] [CrossRef]
- Jaganathan, S.K.; Mandal, M. Involvement of non-protein thiols, mitochondrial dysfunction, reactive oxygen species and p53 in honey-induced apoptosis. Investig. New Drugs 2009, 28, 624–633. [Google Scholar] [CrossRef] [PubMed]
- Carocho, M.; Ferreira, I.C. A review on antioxidants, prooxidants and related controversy: Natural and synthetic compounds, screening and analysis methodologies and future perspectives. Food Chem. Toxicol. 2013, 51, 15–25. [Google Scholar] [CrossRef] [PubMed]
- Hughes-Fulford, M.; Chen, Y.; Tjandrawinata, R.R. Fatty acid regulates gene expression and growth of human prostate cancer PC-3 cells. Carcinogenesis 2001, 22, 701–707. [Google Scholar] [CrossRef]
- Louveaux, J.; Maurizio, A.; Vorwohl, G. Methods of Melissopalynology. Bee World 1978, 59, 139–157. [Google Scholar] [CrossRef]
- Loglio, G.; Formato, G.; Pietropaoli, M.; Jannoni-Sebastianini, R.; Carreck, N.; Van Der Steen, J. An Innovative Home-Made Beebread Collector as a Tool for Sampling and Harvesting. Bee World 2019, 96, 16–18. [Google Scholar] [CrossRef]
- Barros, L.; Pereira, E.; Calhelha, R.C.; Dueñas, M.; Carvalho, A.M.; Santos-Buelga, C. Bioactivity and chemical characterization in hydrophilic and lipophilic compounds of Chenopodium ambrosioides L. J. Funct. Foods 2013, 5, 1732–1740. [Google Scholar] [CrossRef]
- AOAC (Association of Official Agricultural Chemists). The Official Methods of Analysis of AOAC International, 20th ed.; Horwitz, W., Latimer, G., Eds.; AOAC International: Gaithersburg, MD, USA, 2016. [Google Scholar]
- Wiktor, A.; Mandal, R.; Singh, A.; Pratap-Singh, A. Pulsed Light treatment below a Critical Fluence (3.82 J/cm2) minimizes photo-degradation and browning of a model Phenolic (Gallic Acid) Solution. Foods 2019, 8, 380. [Google Scholar] [CrossRef]
- Abedelmaksoud, T.G.; Mohsen, S.M.; Duedahl-Olesen, L.; Elnikeety, M.M.; Feyissa, A.H. Impact of ohmicsonication treat-ment on pectinmethylesterase in not-from-concentrate orange juice. J. Food Sci. Technol. 2019, 56, 3951–3956. [Google Scholar] [CrossRef]
- Abedelmaksoud, T.G.; Mohsen, S.M.; Duedahl-Olesen, L.; Elnikeety, M.M.; Feyissa, A.H. Optimization of ohmicsonication for overall quality characteristics of NFC apple juice. J. Food Process. Preserv. 2019, 43, e14087. [Google Scholar] [CrossRef]
- Altemimi, A.; Al-Hilphy, A.; Abedelmaksoud, T.; Aboud, S.; Badwaik, L.; Noore, S.; Pratap-Singh, A. Infrared Radiation Favorably Influences the Quality Characteristics of Key Lime Juice. Appl. Sci. 2021, 11, 2842. [Google Scholar] [CrossRef]
- Smania, J.A.; Monache, F.D.; Smania, E.D.F.A.; Cuneo, R.S. Antibacterial Activity of Steroidal Compounds Isolated from Ganoderma applanatum (Pers.) Pat. (Aphyllophoromycetideae) Fruit Body. Int. J. Med. Mushrooms 1999, 1, 325–330. [Google Scholar] [CrossRef]
- Farag, M.M.M.; Abd-Allah, W.M.; Ahmed, H.Y.H.Y.A. Study of the dual effect of gamma irradiation and strontium substitution on bioactivity, cytotoxicity, and antimicrobial properties of 45S5 bioglass. J. Biomed. Mater. Res. Part A 2017, 105, 1646–1655. [Google Scholar] [CrossRef] [PubMed]

| Chemical Composition | Free Sugars | % | |
|---|---|---|---|
| Protein | 23.58 ± 0.183 | sucrose | 1.775 ± 0.017 |
| Ash | 2.87 ± 0.108 | glucose | 7.136 ± 0.452 |
| Lipids | 9.45 ± 0.079 | Fructose | 11.355 ± 0.555 |
| Carbohydrates | 64.10 ± 0.391 | Total | 20.266 ± 0.930 |
| Energy | 435.77 ± 2.904 | ||
| Macro Minerals | (mg/100 g) |
|---|---|
| K | 290.202 ± 2.645 |
| P | 215.202 ± 1.103 |
| Ca | 170.200 ± 3.995 |
| Mg | 60.100 ± 4.369 |
| Fe | 31.900 ± 1.153 |
| Na | 11.250 ± 0.687 |
| Zn | 8.730 ± 0.644 |
| Mn | 2.660 ± 0.251 |
| Fatty Acid | Relative Area Percentage (%) |
|---|---|
| Caproic acid (C6:0) | 15.79 ± 0.012 |
| Caprylic acid (C8:0) | 0.42 ± 0.005 |
| Lauric acid (C12:0) | 0.19 ± 0.006 |
| Myristic acid (C14:0) | 0.18 ± 0.005 |
| Myristoleic acid (C14:1 n5) | 0.21 ± 0.006 |
| Pentadecylic acid (C15:0) | 0.09 ± 0.003 |
| Palmitic acid (C16:0) | 20.43 ± 0.083 |
| Margaric acid (C17:0) | 0.29 ± 0.003 |
| Stearic acid (C18:0) | 1.67 ± 0.004 |
| Oleic acid (C18:1n 9) | 3.36 ± 0.004 |
| Linoleic acid (C18:2) | 35.15 ± 0.144 |
| γ-Linolenic acid (C18:3 n6) | 9.45 ± 0.006 |
| α-Linolenic acid (C18:3 n3) | 6.46 ± 0.009 |
| Glycidyl oleate (C21:0) | 6.29 ± 0.008 |
| SFA% | 39.06 ± 0.036 |
| MUFA% | 9.86 ± 0.012 |
| PUFA% | 51.06 ± 0.090 |
| Unknown | 0.02 ± 0.001 |
| Compounds | µg/g | RT |
|---|---|---|
| Gallic acid | 1.60 ± 0.05 | 3.967 |
| p-Hydroxy benzoic acid | 253.64 ± 0.09 | 7.539 |
| Catechin | 11.59 ± 0.03 | 8.773 |
| Vanillic acid | 20.32 ± 0.02 | 9.758 |
| Caffeic acid | 4.198 ± 0.03 | 10.142 |
| Syringic acid | 0.948 ± 0.02 | 10.496 |
| Benzoic acid | 852.20 ± 0.10 | 14.573 |
| Ferulic acid | 207.40 ± 0.08 | 15.374 |
| Rutin | 535.00 ± 0.11 | 16.682 |
| Ellagic acid | 16.34 ± 0.04 | 16.897 |
| o-Coumaric acid | 10.90 ± 0.06 | 17.528 |
| Resveratrol | 53.20 ± 0.07 | 19.346 |
| Cinnamic acid | 313.80 ± 0.09 | 20.123 |
| Quercetin | 717.40 ± 0.17 | 21.639 |
| Myricetin | 24.50 ± 0.06 | 23.312 |
| Kaempferol | 34.02 ± 0.08 | 24.320 |
| Pathogen | Beebread | Standard |
|---|---|---|
| Gram-positive bacteria | Gentamicin | |
| Staphylococcus aureus (ATCC 6538) Bacillus Subtilis (ATCC 6633) | 26 ± 0.81 24 ± 0.53 | 15 ± 0.74 25 ± 0.48 |
| Gram-negative bacteria | Gentamicin | |
| K. pneumoniae (ATCC 13883) Escherichia coli (ATCC 8739) | 12 ± 0.39 18 ± 0.60 | 22 ± 0.75 17 ± 0.37 |
| Fungi | Amphotericin B | |
| Candida albicans (ATCC 10221) Aspergillus niger | 15 ± 0.73 NA | 21 ± 0.59 15 ± 0.64 |
Publisher’s Note: MDPI stays neutral with regard to jurisdictional claims in published maps and institutional affiliations. |
© 2021 by the authors. Licensee MDPI, Basel, Switzerland. This article is an open access article distributed under the terms and conditions of the Creative Commons Attribution (CC BY) license (https://creativecommons.org/licenses/by/4.0/).
Share and Cite
Elsayed, N.; El-Din, H.S.; Altemimi, A.B.; Ahmed, H.Y.; Pratap-Singh, A.; Abedelmaksoud, T.G. In Vitro Antimicrobial, Antioxidant and Anticancer Activities of Egyptian Citrus Beebread. Molecules 2021, 26, 2433. https://doi.org/10.3390/molecules26092433
Elsayed N, El-Din HS, Altemimi AB, Ahmed HY, Pratap-Singh A, Abedelmaksoud TG. In Vitro Antimicrobial, Antioxidant and Anticancer Activities of Egyptian Citrus Beebread. Molecules. 2021; 26(9):2433. https://doi.org/10.3390/molecules26092433
Chicago/Turabian StyleElsayed, Nesren, Hatem Sharaf El-Din, Ammar B. Altemimi, Hanaa Y. Ahmed, Anubhav Pratap-Singh, and Tarek Gamal Abedelmaksoud. 2021. "In Vitro Antimicrobial, Antioxidant and Anticancer Activities of Egyptian Citrus Beebread" Molecules 26, no. 9: 2433. https://doi.org/10.3390/molecules26092433
APA StyleElsayed, N., El-Din, H. S., Altemimi, A. B., Ahmed, H. Y., Pratap-Singh, A., & Abedelmaksoud, T. G. (2021). In Vitro Antimicrobial, Antioxidant and Anticancer Activities of Egyptian Citrus Beebread. Molecules, 26(9), 2433. https://doi.org/10.3390/molecules26092433









